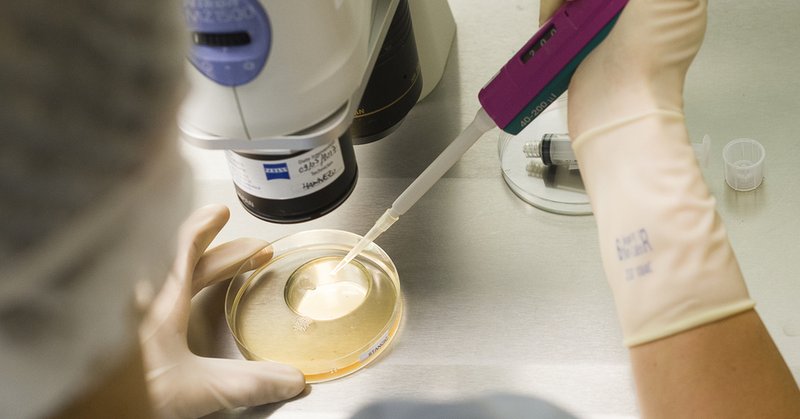
Tweet card summary image

Cécile JAGLIN-GRIMON
@CecileJaglin
Followers
2K
Following
7K
Media
241
Statuses
7K
DG @chu_angers -Pdte Costrat @GHT_49 -DR @FHF_PL -Admin. @HUGrandOuest -VP @le_graph -VP @DG_CHRU *alumni @ScPoBx @EHESP @ED_SciencesPo -Compte personnel
Joined November 2013
Chers amis Je n'ai plus d'activité sur ce réseau. Vous pouvez continuer à me suivre sur #Linkedin @CecileJaglin et #Bluesky @cecilejaglin.bsky.social À bientôt 👋
1
0
0
Retour sur le lancement du Tiers-Lieu d’expérimentation numérique en santé « MOBIS », porté par le @chu_angers. Merci @LesEchos pour cet article. https://t.co/o9mRSpY0kp
lesechos.fr
Avec la création de son tiers-lieu Mobis, l'établissement angevin veut favoriser les collaborations entre professionnels du numérique et acteurs de la santé sur la question des mobilités intelligen...
0
7
15
Le @chu_angers dresse le bilan de trois ans d'intéressement aux services pour soutenir une activité de recherche. @nicolas_riffet explique la méthodologie élaborée par la @DRCI_chuangers. Article de @piahem à lire ici ⬇️
hospimedia.fr
Le CHU d'Angers a fait le choix de développer l'intéressement aux services pour encourager l'activité de recherche. Après avoir redistribué 1,7 million…
0
5
4
🍄 Cueillette de champignons : prudence !🍄 ⚠️ En cas de doute = ne les mangez pas ! Consultez un pharmacien ou une association. 💻 + d'infos sur le site de l'@Anses_fr : https://t.co/Z7XE01nuOW En cas d'intoxication, contactez le Centre Antipoison Angers : 02 41 48 21 21.
0
4
1
Fière d'accompagner les femmes, les publics fragiles, les couples en détresse, les personnes en situation d'handicaps complexes dans l'accès à la santé sexuelle et à l'IVG. 🙏 Dr Lavigne, @MGEN_officiel qui accompagne cet engagement 👏👏👏 Mélusine Vene, artiste sensible
🖌️ Quand la culture rejoint le soin 💉 "Traversée" c'est le nom de l'œuvre artistique inaugurée ce vendredi au Centre de santé sexuelle et d'IVG Flora Tristan au @chu_angers Cette œuvre s'inscrit dans la restructuration et la modernisation du centre qui s'est achevée cet été.
0
2
9
Le roof top d'arborescence sera le lieu idéal pour suivre le chantier #Convergence @chu_angers Etape 1 à partir de novembre : déconstruction des bâtiments de l'emprise chantier
0
0
6
Les hôpitaux publics, par la voix notamment de la @laFHF et de la Conférence des Directeurs généraux de CHRU, alertent dans @LesEchos sur le risque de fragilisation des établissements et de l'offre de soin qu’ils assument. https://t.co/J1DNWBWuFp
lesechos.fr
Sur le papier, l'enveloppe prévue par le gouvernement dans le budget 2025 devrait augmenter l'an prochain. En réalité, les hôpitaux estiment que les moyens supplémentaires devraient être réduits à...
1
3
5
🚨 La privatisation des établissements de santé est associée à de moins bons résultats pour les patients Qui aurait pu l'imaginer ?! Revue de littérature publiée dans theLancet qui analyse les effets de la privatisation dans les pays à revenus élevés https://t.co/rf0STS6eGP
2
419
562
Bravo 👏👏👏
✅La FHF lance son nouveau programme éditorial #SantéetVérités pour contrer la désinformation sur les sujets de santé 👉 basé sur un fact-checking rigoureux et des données fiables, il vise à éclairer le débat public avec précision et transparence⤵️ https://t.co/EkdHvZ2smU
0
1
4
Félicitations chère Madame Au plaisir d'échanger prochainement
Très heureuse de me voir confier le poste de première adjointe, je remercie @ChristopheBechu et toute l’équipe @AngersPourVous. Merci @JM_Verchere pour tes mots et ton engagement pour notre ville @Angers !!
1
1
6
L'occasion de présenter la dynamique prévention et promotion de la sante @chu_angers , la démarche #HAVISAINES dédiée aux professionnels du CHU et peut-être de porter les conditions de déploiement du #MECC à l'hôpital
Prévention : le défi du siècle. La #SoiréedesHopitaux c'est ce soir à 18h. Retrouvez les conférences et débats sur le sujet, en présence de @CecileJaglin, Directrice Générale du #CHUAngers ⤵️
0
0
2
Prévention : le défi du siècle. La #SoiréedesHopitaux c'est ce soir à 18h. Retrouvez les conférences et débats sur le sujet, en présence de @CecileJaglin, Directrice Générale du #CHUAngers ⤵️
La soirée des Hôpitaux 2024 organisée par @LePoint, c'est ce soir ! Il est encore temps de vous inscrire pour participer au grand débat sur l'Hôpital français ➡️ https://t.co/WM4erwxWqG Politiques, experts et professionnels de santé se réunissent pour partager leurs
0
1
0
Très heureuse d'avoir participé à cet échange riche et constructif sur les évolutions des besoins de santé au sein des territoires, les initiatives de terrain à l'initiative des #GHT notamment
#UEFHF2024 | 🗣️ Dernière table-ronde de la journée sur le thème "l'heure de vérité : sur le terrain, réorganiser l'offre de soins à l'épreuve des faits" avec ⤵️ ✔️@CecileJaglin, DG du @chu_angers ✔️Claire Peigné, Maire de Morancé, Conseillère régionale Auvergne Rhône Alpes,
0
1
14
📢Vaccination contre le virus #Mpox🦠 Les CeGIDD du CHU Angers et du CH de Cholet proposent des créneaux de vaccination préventive pour les personnes à risque, sur rdv : 🔹 CeGIDD Angers : 02 41 35 32 24 🔹 CeGIDD Cholet : 02 41 49 68 81 + infos sur : https://t.co/6wzVX7W2Is
0
3
3
#ConsignesSanitaires | Face à la recrudescence des cas de #Coqueluche, le CHU renforce les mesures préventives pour protéger les nouveau-nés et les nourrissons ⤵️ En savoir➕: https://t.co/9reHRX3UWK
0
5
3
#Santé : « la population a un peu oublié que la #coqueluche présente un risque mortel pour le nourrisson ». Via @courrierouest . @chu_angers @CecileJaglin @ars_pdl
ouest-france.fr
Pneumo-pédiatre au CHU d’Angers, Françoise Troussier rappelle, à quelques semaines de la rentrée, que la coqueluche présente un risque mortel pour le nourrisson de moins de six mois ainsi que...
0
3
4
#ConsignesSanitaires | Face à la recrudescence des cas de #Coqueluche, le CHU renforce les mesures préventives pour protéger les nouveau-nés et les nourrissons ⤵️ En savoir➕: https://t.co/9reHRX3UWK
0
2
4